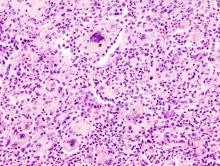
ACSH article image

Whether your goal is to increase strength, decrease body fat or improve overall performance, adding supplements to your daily regimen can give you that extra edge. But with thousands of products on the market, choosing the ones that are right for you can be overwhelming.
That said, here are some of the more popular supplements on the market today, separated into three categories:
Whether your goal is to increase strength, decrease body fat or improve overall performance, adding supplements to your daily regimen can give you that extra edge. But with thousands of products on the market, choosing the ones that are right for you can be overwhelming.
That said, here are some of the more popular supplements on the market today, separated into three categories: